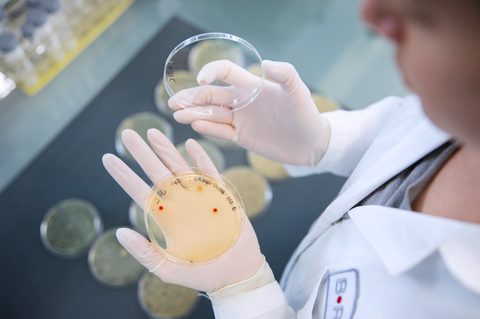
Kulturplatte nach Genome Editing mit BEC high res
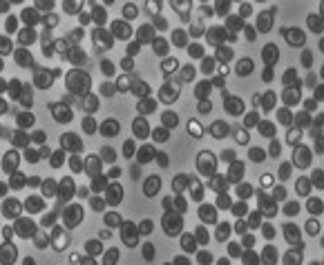
P Xtra

Fermentation as a scalable technology starts with the microorganisms that act as factories in which cells are capable of producing very precise ingredients through very rapid duplication. Fermenting enzymes requires the synergy between protein of interest and microorganisms. Different enzyme classes, and even different classes of enzymes from the same class, are known to be better suited to specific microorganisms. To achieve optimum production yield of the enzyme, genetic engineering or evolutionary optimisation methods can be explored to best reach target strain productivity.

For the production of enzymes and proteins, we access prokaryotic host organisms (including Escherichia coli, Bacillus subtilis, Pseudomonas stutzeri, Streptomyces lividans and Corynebacterium glutamicum) and eukaryotic host organisms (including Pichia pastoris, Kluyveromyces lactis and Aspergillus niger). For the expression of a gene of interest, the gene can be inserted into an expression host via BRAIN’s metagenomic Cas nuclease BMC (proprietary CRISPR-Cas) or classical methods utilising different auxotrophic and antibiotic selection markers.

Aurase® Wound Gel showing strong clinical evidence of superior debridement and healing in chronic wounds

From maximising extract and improving lauter performance to supporting yeast health, clarity and shelf stability, enzymes quietly solve some of the brewing industry’s toughest challenges.

BRAIN Biotech AG, a leading provider of specialised enzymes and innovative biosolutions for industry, has published the BRAIN Biotech Group´s financial figures for the fiscal year 2024/25.

Discover how targeted enzymatic conversion of soy lecithin into high-performance lysolecithin enhances functionality, stability, and commercial value.

Still catching up on everything from Food Ingredients Europe? Read our key take aways from the event and where the food ingredient industry appears to be heading for the next 12 months.

Unlocking the full potential of sunflower lecithin through targeted phospholipase A2 conversion to high-performance lyso-lecithin

From sustainable biocatalysis to AI-driven enzyme discovery and the ongoing challenge of scaling up from lab to production, CPHI 2025 showcased how fast the industry is evolving, and how collaboration between discovery, strain development, and process engineering is now critical for real progress. Read our full event round up.

We caught up on the latest breakthroughs at the Future of Protein Production summit, where it’s clear the race to reinvent how we produce protein is well underway. Here’s a snapshot of the key trends, technologies, and takeaways shaping the future of food.



